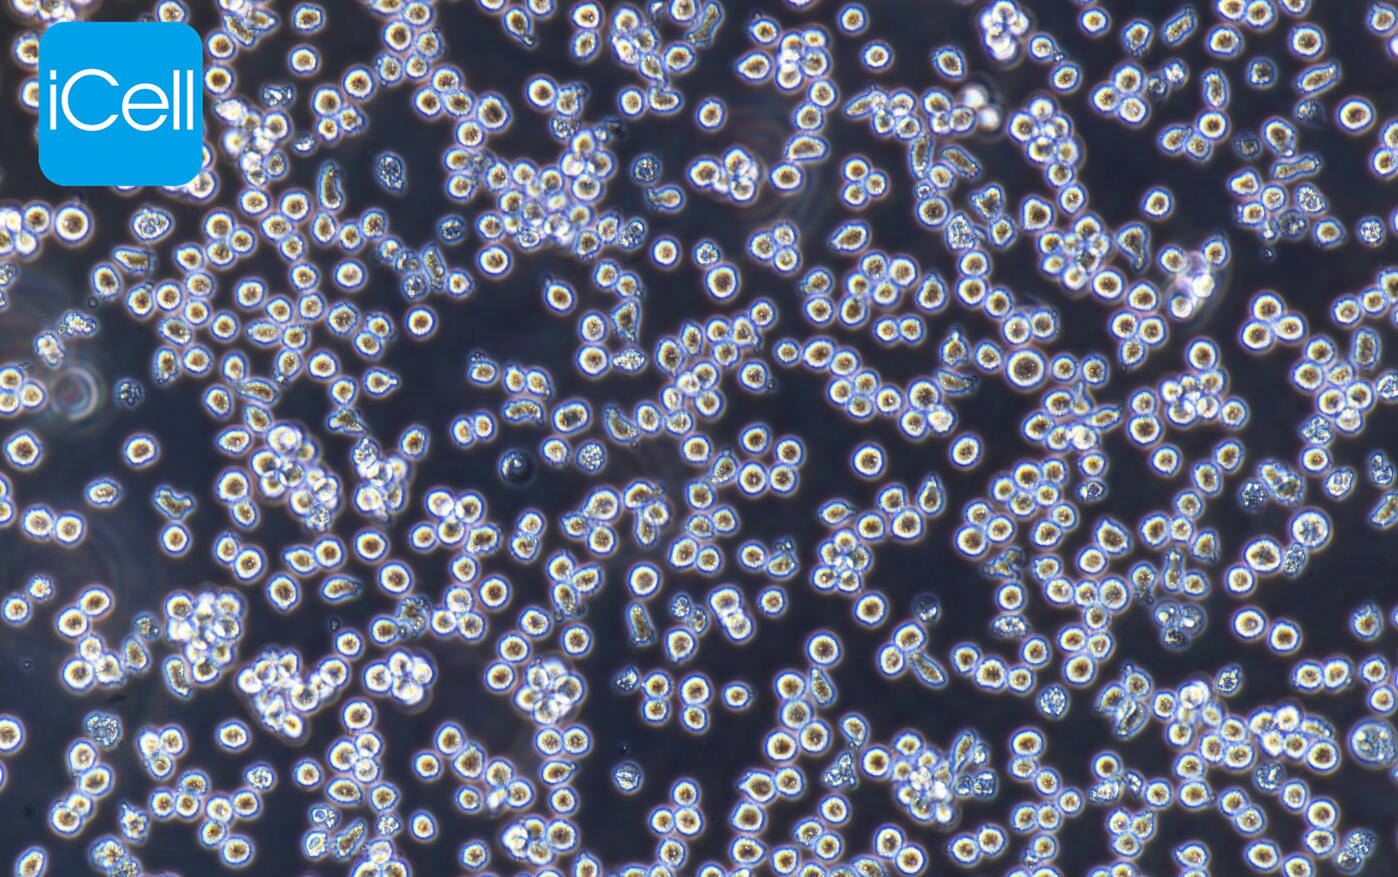
MOLT-4 | MOLT-4细胞 | MOLT4细

相关产品推荐更多 >
万千商家帮你免费找货
0 人在求购买到急需产品
- 详细信息
- 文献和实验
- 技术资料
- 英文名:
MOLT-4 MOLT4
- 库存:
100
- 供应商:
镜像绮点
- 肿瘤类型:
白血病
- 细胞类型:
细胞系
- ATCC Number:
-
- 品系:
细胞系
- 组织来源:
淋巴母细胞
- 相关疾病:
白血病
- 物种来源:
组织
- 免疫类型:
否
- 细胞形态:
淋巴母细胞样
- 是否是肿瘤细胞:
是
- 器官来源:
淋巴母细胞
- 运输方式:
冻存/复苏
- 年限:
长期
- 生长状态:
悬浮生长
- 规格:
T25
细胞介绍
该细胞株从一位复发病人的细胞中建立。该病人接受过多种药物联合前期化疗。p53基因的248位密码子有一个G-A突变。P53不表达,不生成免疫球蛋白或EB病毒。
细胞特性
1) 来源:T 淋巴母细胞
2) 形态:淋巴母细胞样,悬浮生长
3) 含量:>1x10^6 细胞数
4) 规格:T25瓶或者1mL冻存管包装
5) 用途:仅供科研使用。
一.培养基及培养冻存条件准备:
1) 准备RPMI-1640(含NaHCO3 1.5g/L推荐iCell-128-0002 或者GIBCO,货号31800022, 添加NaHCO3 1.5g/L,或者ATCC-formulated RPMI-1640 Medium, Catalog No. 30-2001 ATCC 改良)培养基;优质胎牛血清,10%;双抗,1%。
注意:该细胞在1640(含1.5g/LNaHCO3)培养基中生长良好,大部分品牌的1640含有较高浓度的NaHCO3(3.7g/L),若使用1640(3.7g/L NaHCO3)培养基培养细胞时需要提高CO2浓度(7%-10%)。
2) 培养条件: 气相:空气,95%;二氧化碳,5%。 温度:37摄氏度,培养箱湿度为70%-80%。
3) 冻存液:90%血清,10%DMSO,现用现配。
对于悬浮细胞,传代可参考以下方法:
悬浮状态下生长的细胞,可以通过向培养瓶中添加完全培养基来维持细胞的生长状态,一般情况下细胞密度维持在1×105~1×10^6个/mL(不同细胞对密度要求不同,)可以维持细胞的正常生长。如需分瓶可以将细胞悬液收集到离心管中1000rpm,离心5min,弃去上清,补加1-2mL培养液后重悬混匀后将细胞悬液按1:2的比例分到新T25瓶中,添加6-8ml按照说明书要求配置的新的完全培养基以保持细胞的生长活力,后续传代根据实际情况按1:2~1:5的比例进行。
3) 细胞冻存: 收到细胞后建议在培养前3代时冻存一批细胞种子以备后续实验使用。
业务范围



风险提示:丁香通仅作为第三方平台,为商家信息发布提供平台空间。用户咨询产品时请注意保护个人信息及财产安全,合理判断,谨慎选购商品,商家和用户对交易行为负责。对于医疗器械类产品,请先查证核实企业经营资质和医疗器械产品注册证情况。
文献和实验查询:www.icellbioscience.com/news/News/blog/1
技术资料









